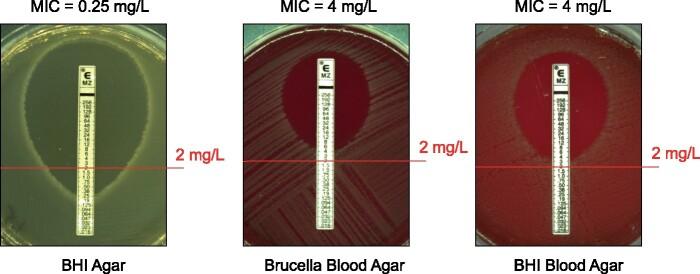

血红素对于艰难梭菌临床分离株中依赖培养基的甲硝唑耐药性至关重要。
Haem is crucial for medium-dependent metronidazole resistance in clinical isolates of Clostridioides difficile.
作者信息
Boekhoud Ilse M, Sidorov Igor, Nooij Sam, Harmanus Céline, Bos-Sanders Ingrid M J G, Viprey Virginie, Spittal William, Clark Emma, Davies Kerrie, Freeman Jane, Kuijper Ed J, Smits Wiep Klaas
机构信息
Department of Medical Microbiology, Leiden University Medical Center, Leiden, The Netherlands.
Center for Microbiome Analyses and Therapeutics, Leiden University Medical Center, Leiden, The Netherlands.
出版信息
J Antimicrob Chemother. 2021 Jun 18;76(7):1731-1740. doi: 10.1093/jac/dkab097.
BACKGROUND
Until recently, metronidazole was the first-line treatment for Clostridioides difficile infection and it is still commonly used. Though resistance has been reported due to the plasmid pCD-METRO, this does not explain all cases.
OBJECTIVES
To identify factors that contribute to plasmid-independent metronidazole resistance of C. difficile.
METHODS
Here, we investigate resistance to metronidazole in a collection of clinical isolates of C. difficile using a combination of antimicrobial susceptibility testing on different solid agar media and WGS of selected isolates.
RESULTS
We find that nearly all isolates demonstrate a haem-dependent increase in the MIC of metronidazole, which in some cases leads to isolates qualifying as resistant (MIC >2 mg/L). Moreover, we find an SNP in the haem-responsive gene hsmA, which defines a metronidazole-resistant lineage of PCR ribotype 010/MLST ST15 isolates that also includes pCD-METRO-containing strains.
CONCLUSIONS
Our data demonstrate that haem is crucial for medium-dependent metronidazole resistance in C. difficile.
背景
直到最近,甲硝唑仍是艰难梭菌感染的一线治疗药物,目前仍被广泛使用。虽然已报道因质粒pCD-METRO导致耐药,但这并不能解释所有病例。
目的
确定导致艰难梭菌质粒非依赖性甲硝唑耐药的因素。
方法
在此,我们使用不同固体琼脂培养基上的抗菌药物敏感性试验和选定菌株的全基因组测序相结合的方法,研究了一组艰难梭菌临床分离株对甲硝唑的耐药性。
结果
我们发现几乎所有分离株对甲硝唑的最低抑菌浓度(MIC)均呈现血红素依赖性增加,在某些情况下导致分离株被判定为耐药(MIC>2mg/L)。此外,我们在血红素反应基因hsmA中发现了一个单核苷酸多态性(SNP),它定义了PCR核糖体分型010/多位点序列分型ST15分离株的甲硝唑耐药谱系,其中还包括含有pCD-METRO的菌株。
结论
我们的数据表明,血红素对于艰难梭菌中培养基依赖性甲硝唑耐药至关重要。